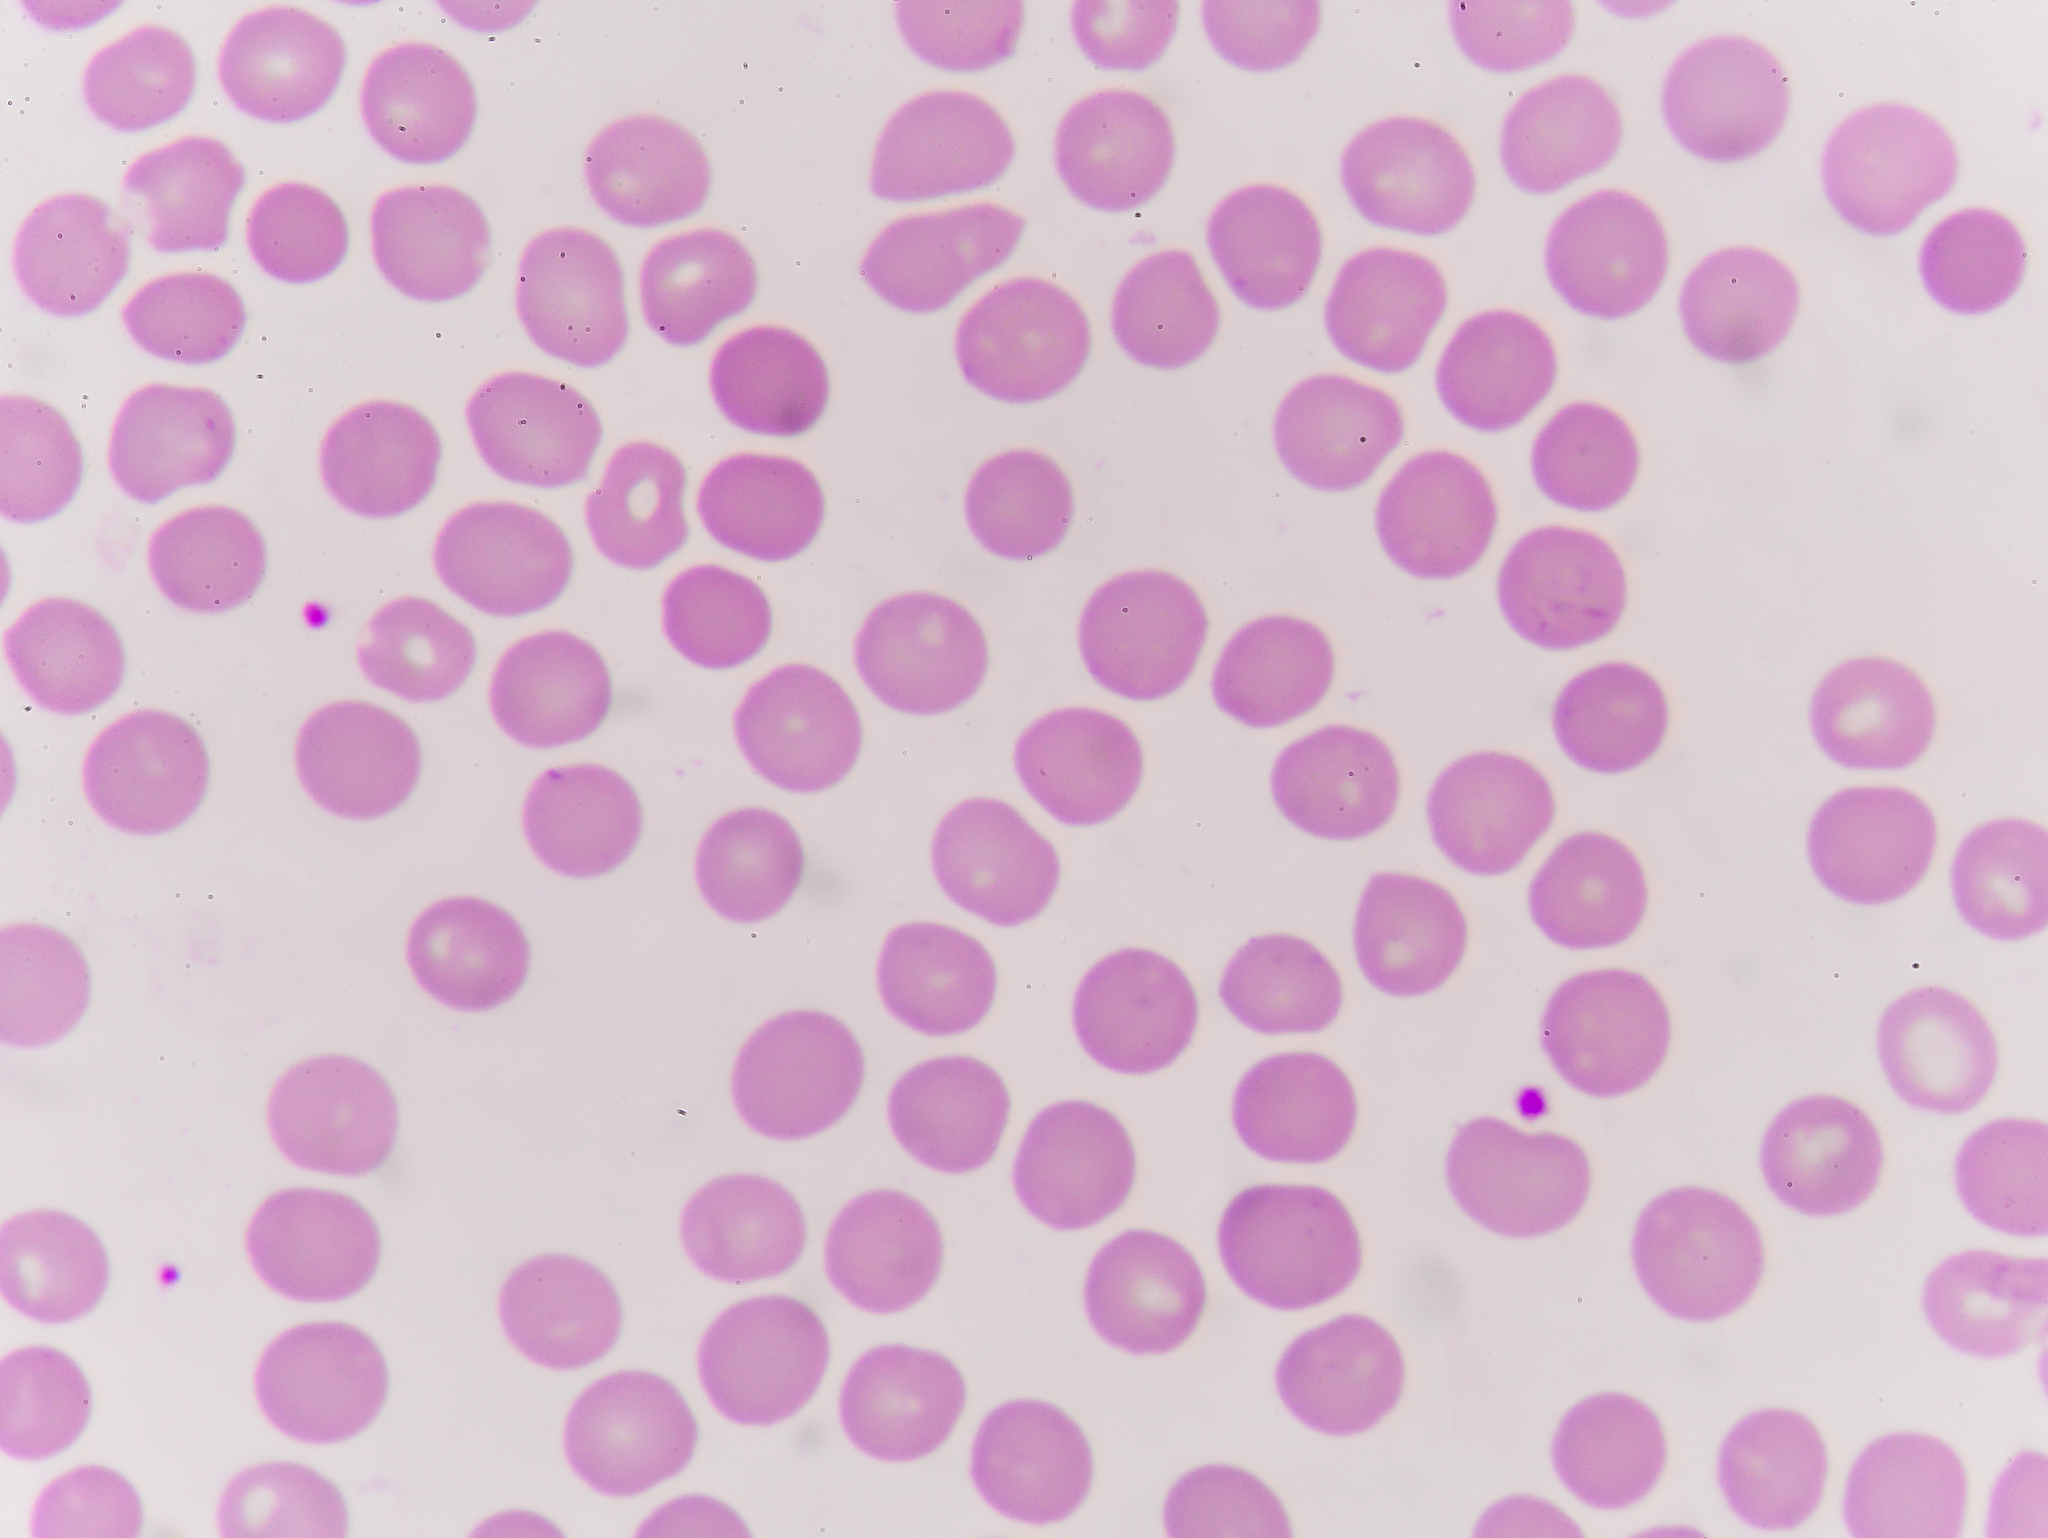
促红细胞生成素：了解这个神奇激素如何调节血红蛋白合成

促红细胞生成素:了解这个神奇激素如何调节血红蛋白合成
促红细胞生成素:了解这个神奇激素如何调节血红蛋白合成
在我们的身体中,存在一种神奇的激素叫做促红细胞生成素(Erythropoietin,EPO),它在调节血红蛋白合成中扮演着至关重要的角色。血红蛋白是红细胞中的一种关键蛋白质,负责将氧气从肺部输送到全身组织。本文将深入解析促红细胞生成素的功能,并探究其在人体中的作用机制。
促红细胞生成素的来源和作用机制
促红细胞生成素主要由肾脏和肝脏中的特定细胞产生。当身体处于缺氧状态时,比如身处高海拔地区或肺部功能受损时,肾脏和肝脏就会释放促红细胞生成素进入血液循环。这种缺氧信号会启动一系列生物反应,其中之一就是促红细胞生成素的释放。
促红细胞生成素主要作用于骨髓中的造血干细胞。一旦促红细胞生成素与其受体结合,便会激活一条信号传导通路,促使造血干细胞分化成红细胞前体细胞。这些前体细胞随后进一步发育成成熟的红细胞,这些红细胞富含血红蛋白,可以携带和运输氧气。
促红细胞生成素的多重功能
除了刺激红细胞生成外,促红细胞生成素还具有其他重要的功能:
- 延长红细胞的生命周期,增加红细胞在循环中的存在时间,意味着更多的红细胞能够携带氧气,为身体各个组织提供更多氧气供应。* 提高红细胞的弹性,使其更容易通过微小的血管,进一步促进氧气的输送。
促红细胞生成素的临床应用
促红细胞生成素在某些疾病治疗中发挥着关键作用。例如:
- 在一些患有严重贫血的患者中,医生可能会使用合成的促红细胞生成素作为药物来增加红细胞的数量。* 促红细胞生成素也被用于治疗一些与慢性肾脏疾病相关的贫血情况。
促红细胞生成素的使用注意事项
值得注意的是,促红细胞生成素的使用必须严格控制。过度使用该激素可能导致红细胞过多,造成血液黏稠度增加,增加心血管疾病的风险。因此,在临床应用中,医生会根据患者的具体情况和需要,精确调整促红细胞生成素的用量。
总结
促红细胞生成素是一个非常重要且神奇的激素,它通过调节红细胞的生成、寿命和功能,确保我们的身体能够正常运行并获得足够的氧气供应。对于那些患有贫血或其他相关疾病的患者来说,促红细胞生成素可能是一种有效的治疗方法。然而,我们也必须谨慎使用,以避免潜在的健康风险。
希望通过本文,您对促红细胞生成素的功能和作用机制有了更深入的了解。如果您有任何进一步的问题,请随时向我们咨询。
原文地址: https://www.cveoy.top/t/topic/hSP 著作权归作者所有。请勿转载和采集!